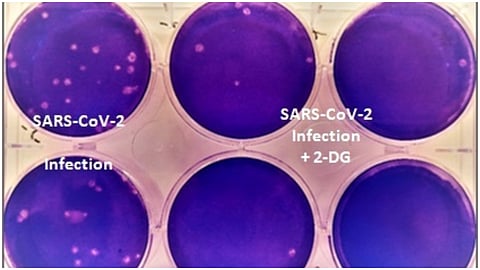

नवी दिल्ली : DRDO नं विकसित केलेलं DG-2 हे औषध कोरोनावर प्रभावी असल्यानं त्याला कोरोनाच्या रुग्णांवर वापरासाठी नुकतीच परवानगी देण्यात आली आहे. त्यासाठी हे औषध आता बाजारातही आलं आहे. पण DRDO नं खास करुन कोरोनासाठी विकसित केलेलं हे औषध नाही, यापूर्वी हे औषध कर्करोगाच्या आजारावरही वापरण्यात आलं आहे. आयसीएमआरचे महासंचालक बलराम भार्गव यांनी ही माहिती दिली आहे. (DRDO 2 DG drug is a repurposed medicine not a new says ICMRs Dr Balram Bhargava)
भार्गव यांनी सांगितलं की, DRDO चं DG-2 हे औषध मूळतः कर्करोगावरील उपचारांसाठी तयार करण्यात आलं होतं. कर्करोगावर त्याचा वापरही करण्यात आला आहे. हेच औषध सध्या कोरोनावरही परिणामकारक असल्याचं चाचण्यांमध्ये दिसून आलं. त्यामुळे त्याच्या कोरोना रुग्णांवर वापरासाठीही DCGI नं परवानगी दिली आहे. त्यामुळे हे औषध नवं औषध नाही तर जुनचं औषध असून त्याचा पुन्हा वेगळ्या आजारावर वापर केला जाणार आहे.
डीआरडीओच्या इन्स्टिट्यूट ऑफ न्युक्लिअर मेडिसिन अँड अलाईड सायन्सेस (INMAS) आणि हैदराबादच्या डॉ. रेड्डी लॅबोरिटरीजच्या सहकार्याने बनवण्यात आलेल्या 2-DG या कोविड प्रतिबंधक औषधाला केंद्र सरकारच्या ड्रग्ज कन्ट्रोलर जनरल ऑफ इंडिया (DGCI) या विभागानं नुकतीच मंजुरी दिली. हे कोविड प्रतिबंधक औषध तौडाद्वारे घेता येणारं औषध असून यामुळे कोविडचे रुग्ण लवकर बरे होत असल्याचं क्लिनिकल ट्रायलमध्ये सिद्ध झालं आहे.
क्लिनिकल ट्रायल्समध्ये हे सिद्ध झालंय की, 2-DG हे औषध जे रुग्ण रुग्णालयांमध्ये उपचार घेत आहेत तसेच जे रुग्ण सिलिंडरमधील ऑक्सिजन अवलंबून आहेत त्यांना हे औषध घेतल्यानंतर ऑक्सिजनची गरज कमी होऊ शकते. ज्या रुग्णांना 2 DG हे औषध दिलं जातंय त्यांची आरटी-पीसीआर चाचणी निगेटिव्ह येण्याचं प्रमाणंही जास्त आहे.
पंतप्रधान नरेंद्र मोदी यांनी कोरोनाच्या पहिल्या लाटेवळी या महामारीशी लढण्यासाठी तयारी करण्याचे विविध घटकांना आवाहन केलं होतं, तेव्हा डीआरडीओनं एप्रिल २०२०मध्ये 2-DG य औषधावर काम करायला सुरुवात केली होती. त्यानंतर या औषधाच्या क्लिनिकल ट्रायल्सदरम्यान आढळून आलं की, हे औषध SARS-Cov-2 (कोविड-१९) या आजारावर प्रभावीपणे काम करते. दरम्यान, या औषधाच्या फेज-२ मधील क्लिनिकल ट्रायलला मे २०२० मध्ये परवानगी दिली होती. त्यानंतर मे-ऑक्टोबर २०२० मध्ये डीआरडीओ आणि डॉ. रेड्डी यांनी मिळून फेज-२ च्या ट्रायलला सुरुवात केली होती. फेज-२ची ट्रायल ६ रुग्णालयांमध्ये घेण्यात आली यामध्ये ११० रुग्णांवर याची चाचणी झाली.
सकाळ+ चे सदस्य व्हा
ब्रेक घ्या, डोकं चालवा, कोडे सोडवा!
शॉपिंगसाठी 'सकाळ प्राईम डील्स'च्या भन्नाट ऑफर्स पाहण्यासाठी क्लिक करा.
Read latest Marathi news, Watch Live Streaming on Esakal and Maharashtra News. Breaking news from India, Pune, Mumbai. Get the Politics, Entertainment, Sports, Lifestyle, Jobs, and Education updates. And Live taja batmya on Esakal Mobile App. Download the Esakal Marathi news Channel app for Android and IOS.